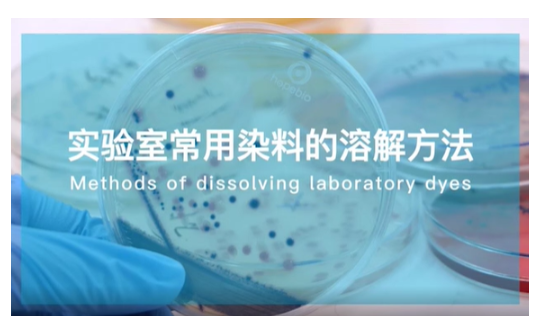

蛋白质毒素结晶试验
蛋白质毒素结晶试验
什么是蛋白质毒素结晶试验:
在GB4789.14标准中,在进行蜡样芽胞杆菌鉴定时蜡样芽胞杆菌与苏云金芽孢杆菌生化反应相同,但苏云金芽孢杆菌在形成芽孢的同时,会在芽孢旁形成一颗菱形、方形或不规则形的碱溶性蛋白质晶体,称为伴孢晶体,该晶体易被碱性染料着色,因此常用0.5%碱性复红染料进行染色观察。而蜡样芽胞杆菌和其他芽孢杆菌不产生伴孢晶体。这个染色实验就是蛋白质毒素结晶试验。
操作步骤:
培养芽孢:将待测菌株接种至硫酸锰营养琼脂平板,30±1℃培养24±2h,并于室温放置3-4天。若芽孢产生不丰富,可在室温继续放置2-3天后观察。
原理:芽孢杆菌在营养条件缺乏时,开始形成芽孢,因此在进行细菌产芽孢相关试验时,通常需进行5-7天的放置或培养,待培养基内营养耗尽,可获得更丰富的芽孢。
制片染色:挑取培养物少许于载玻片上,滴加蒸馏水混匀并涂成薄膜。经自然干燥,微火固定后,加甲醇作用 30 s 后倾去,再通过火焰干燥,于载玻片上滴满 0.5%碱性复红,放火焰上加热(微见蒸气,勿使染液沸腾)持续 1 min~2 min,移去火焰,再更换染色液再次加温染色 30 s,倾去染液用洁净自来水彻底清洗、晾干后镜检。观察有无游离芽胞(浅红色)和染成深红色的菱形蛋白结晶体。
(注:在菌苔生长密集的地方营养消耗更快,更容易产生芽孢,因此挑取密集生长处的菌苔制片易观察到更多芽孢)
咨询
我们尊重知识产权,如您认为本平台所载文章、图片、视频等内容侵犯您的合法权益,请您及时联系我们,我们将依据相关法律法规、平台规则予以处理。
关键字
- 473
- 点赞
- 复制链接
- 举报